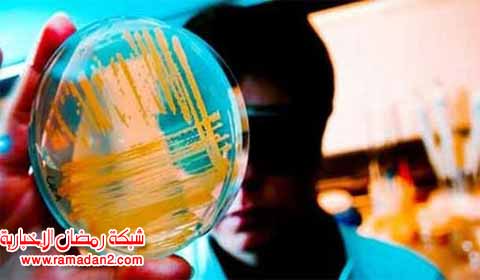
Moba-vom-Himmel24

اجتمعت بعض المواهب البشرية المذهلة، جنباً إلى جنب والجهود الأكثر إبداعاً في العالم لتبتكر طرقا جديدة أكثر فعالية لقتل و إبادة البشر. فيما يلي نستعرض، ما نشره الكاتب ميكي رين بموقع “Atchuup”، من نماذج للأسلحة الأكثر فتكاً من أي وقت مضى عبر التاريخ حول العالم:

1- مدفع مكسيم الرشاش Maxim Machine Gun
اخترعه سير هيرام ستيفنز مكسيم في عام 1884، وهو أولمدفعرشاش يعمل بالارتداد، وقد غير تاريخ عالمنا إلى الأبد. ويمكنه أن يطلق 600 دفعة في الدقيقة الواحدة مما يتسبب في مقتل الآلاف من الأعداء. وتعد المرة الأكثر شهرة التي استخدم فيها كانت خلال معركة شانغاني، حيث قاتل 700 جندي بريطاني ضد 3000 محارب، باستخدام 4 فقط من مدافع مكسيم.

2- بومهارت فون شتاير Pumhart von Steyr
يعتبر أكبر سلاح تم استخدامه قبل أي وقت مضى في القرن 15 في النمسا. يبلغ حجم طلقته 80 سم، وكان يعرف باسم المدفع السوبر الوحشى، الذي كان يبث الخوف في قلوب الأعداء. ويمكنك أن ترى واحداً من هذه المدافع اليوم في متحف هيريز جيشيش تليتشس بفيينا.

3- الهاون الوحش Monster Mortar
أنتجته فرنسا عام 1832. واخترعه ضابط مدفعي فرنسي يدعى هنري-جوزيف بايكسانس. وكان لهاون الوحش يطلق قنابل من زنة 500 كغم، وكان يستخدم لإحداث آثار مدمرة ومروعة في حصار أنتورب في العام 1832.

4- مدفع القيصر Tsar Cannon
صنع في العام 1586، وهو أكبر مدفع شهده التاريخ. يبلغ وزنه 38 طناً ويبلغ طوله 5.34 متراً. ويعرض حالياً بالكرملين في موسكو، روسيا.

5- الدبابة مارك الأول Mark I
مارك الأول هي أول مركبة حرب سميت بالدبابة. ويمكن أن تحمل 5 رشاشات و8 جنود. وعلى مدار تاريخها، شهدت الدبابات عدة تحسينات تصل إلى 10 تجديدات. وخلال الحرب العالمية الأولى قامت العديد من البلدان باستخدام الدبابة ومتغيراتها.

6- كارل جيرات Karl Gerat
هو أكبر سلاح ذاتي الدفع يتم تدشينه خلال الحرب العالمية الثانية. قامت مصانع “راينميتال” بإنتاج هذه الآلة الوحشية لحساب النازيين.

7- شفيرر غوستاف ودورا Schwerer Gustav and Dora
وهذان المدفعان الألمانيان بالغا الضخامة كانا يتحركان على قضبان حديدية سعة 80 سم، وهما من أكبر الأسلحة عياراً على مستوى العالم، التي تم استخدامها في قتال حي خلال الحرب العالمية الثانية. كما أن قذائفهما هي الأثقل من نوعها في التاريخ.

8- مدفع آر بى جيه-71 RPG-71
آر بي جيه (Ruchnoy Protivotankovyy Granatomyot) قاذف قنابل محمول باليد مضاد للدبابات. هو السلاح الأكثر استخداماً على نطاق واسع حالياً مضاداً للدبابات وللعربات المدرعة بصفة عامة. وتلجأ إليه القوات العسكرية وأفراد الجماعات المتمردة على حد سواء حتى خارج ساحة المعركة، وبخاصة ضد الأعداء المسلحين بمدفعية ثقيلة.

9- بي41 (إم كيه-41) B41 (MK-41)
بي41 هو سلاح نووي حراري، عبارة عن رؤوس نووية تعد الأقوى بين ما قامت بتصنيعها الولايات_المتحدة في تاريخها. بي41 هي قنبلة شديدة الخطورة، ذات كتلة من 4800 كغم حيث يبلغ طولها حوالى 4 أمتار وقطرها 1.32 متر. طائرات B-52 ستراتوفورترس و47B- ستراتوجيت فقط هي التي كانت تحمل الرؤوس النووية-الحرارية بي41، التي خرجت من الخدمة عام 1957.

10- الصاروخ بي-270 موسكيت P-270 Moskit
يتميز هذا الصاروخ بسرعة قصوى تصل إلى ماخ-3، بما يعادل 3 أضعاف سرعة الصوت. وهو صاروخ روسي الصنع، نفاث أسرع من الصوت، عابر للقارات، يصعب على الأعداء مواجهة هجومه. ونظراً لسرية الأسلحة العسكرية في الخدمة، لا يُعرف سوى القليل جداً عن خلفية السلاح باستثناء النزر اليسير من المعلومات الأساسية.

11- بي- 800 أونيكس P-800 Onyx
سجل هذا السلاح سرعات مذهلة بين ماخ-2.9 وتصل إلى ماخ-5.7. P-800 هو صاروخ كروز أسرع من الصوت، روسي مضاد للسفن. وهناك مزاعم أنه قادر على إغراق حاملة طائرات أميركية.

12- صاروخ أغني The Agni missile
تنتمي صواريخ أغني، التي صنعتها الهند إلى فئة الصواريخ البالستية المتوسطة إلى العابرة للقارات. ويسمى هذا الصاروخ باسم أحد العناصر الخمسة للطبيعة.

13- الرجل السمين والصبي الصغير Fat Man and Little Boy
أسقطت هاتان القنبلتان النوويتان سيئتا السمعة على هيروشيما و ناغازاكي خلال الحرب العالمية الثانية، مما غير مسار تاريخ العالم. خلفت هذه القنابل النووية المروعة، اللتان أٌطلق عليهما أسماء شخصيات أحد الأفلام السينمائية، الذكريات الأكثر إثارة للصدمة، لما يمكن أن تقوم به الحرب النووية في العالم.

14- القنبلة بي53 B53
تحتوي تلك القنبلة على 9 أطنان من “تي إن تي” وهي واحدة من أقوى القنابل النووية-الحرارية الأميركية ذات القدرة التدميرية العالية في الولايات المتحدة. ولم يعد يتم استخدام بي53 بنشاط مؤخراً.

15- “أم القنابل” MOAB/GBU-43/B Massive Ordinance Air Blast
يطلق عليها اسم “أم القنابل”، ورسمياً فإن اسمها “قنبلة الذخائر المكثفة الانفجارية بالهواء”. وهي عبارة عن قنبلة تزن 9525 كغم. تعتبر أقوى سلاح غير نووي صنع فى أي وقت مضى لحساب الجيش الأميركي. ويمكن للانفجار الذي تحدثه “أم القنابل” أن يدمر 9 تجمعات سكنية فى دائرة نصف قطرها 137.61 متر.
وهو سلاح غير مخصص لاختراق التحصينات والموانع الجغرافية الطبيعية، إنما الغرض منه هو تدمير أهداف أفقية في مساحة أرض واسعة، كتجمعات العتاد والجنود معا، أو الأهداف المحمية أو المخبأة في التضاريس الجبلية، أو حتى في الوديان العميقة، عبر صعق ما في “بطنها” لما وزنه 8164 كغم من متفجرات يسمونها Tritonal المعروفة كخليط خطير نسبته 80% من مادة TNT و20% من مسحوق الألومنيوم، المساعد على زيادة سرعة انفجار “تي أن تي” لزيادة الضغط الناتج عن التفجير نفسه.
استخدمتها القوات الأميركية ضد عصابات دواعش في أفغانستان منتصف إبريل/نيسان 2017.

16 -“أبو القنابل” FOAB or Aviation Thermobaric Bomb of Increased Power (ATBIP)
يطلق هذا السلاح الحراري الروسي جو/أرض، ويسمى “أبو القنابل”. وله أثره المدمر الهائل، ويقال إن له تأثيراً تخريبياً هائلاً “لدرجة أن كل ما هو على قيد الحياة يتعرض للتبخر عند انفجاره”.
وتقدر قوة القنبلة الروسية بأنها تتجاوز 4 مرات قوة “أم القنابل” الأميركية، مع قدرة تفجير تصل إلى 44 طناً من مادة “تي إن بي” بالمقارنة بـ11 طناً من المادة نفسها في القنبلة الأميركية. وزن القنبلة الروسية يبلغ 7100 كغم.

17- القيصر بومبا أو “ملك القنابل” Tsar Bomba
“ملك القنابل”.. قنبلة لها كتلة من 27 طناً، وتحدث كرة نارية فى دائرة نصف قطرها 3.5 كم، وتمتد على بعد 60 كم في السماء. ربما تكون رأيت تلك الانفجارات على شكل سحابات عش الغراب الهائلة في كتب التاريخ. وتسببت هذه القنبلة الهائلة في إحداث تلك السحب، عندما قامت روسيا باختبارها في عام 1961.

18- “نيميتز” حاملة الطائرات Nimitz Class Aircraft Carrier
حاملة الطائرات “نيميتز” على حد سواء ضخمة في الحجم ومدمرة للغاية من حيث القوة. تتميز بمفاعلين نوويين توأمين، ولذا لا تحتاج للتزود بالوقود لمدة 23 عاماً. ويمكن لسطحها أن يتسع لـ 130 طائرة من طراز أف/إيه-18 هورنتس. تسبق “نيميتز” سمعة مخيفة للغاية، لدرجة أن مجرد ظهورها في منطقة ما غالبا ما يكون كافياً للتأثير على السياسة العالمية وردع المعتدين دون أن تنفذ أي عمليات قتالية.

19-الليزر / بوينج ييل-1 المحمولة جوا The Airborne Laser/Boeing YAL-1
إن مشاهدي سلاسل أفلام “حروب الكواكب” لا شك سوف يعجبون بمثل هذا السلاح. إن الليزر ييل-1 المحمولة جوا عبارة عن بوينغ 747 مع ليزر ضخمة موضوعة على مقدمتها. وهي مصممة مع نظام الدفاع الصاروخي لتدمير الصواريخ الباليستية التكتيكية ولإسقاط صواريخ العدو من على بعد مئات الأميال. إنها سلاح ثوري مع القدرة الفورية على تدمير الأهداف عالية السرعة التي تتحرك على مسافة بعيدة للغاية.

20- المفترس والمفترس The Predator and Predator B (aka The Reaper)
المعروف ببساطة باسم الطائرات بدون طيار، وتستخدمها عادة الولايات المتحدة، والقوات الجوية الملكية، والقوات الجوية الإيطالية لعمليات القتال والاستطلاع على حد سواء.

21- الصاروخ “ترايدنت الثاني” The Trident II D5 SLBM
يحتوي الصاروخ على 8 رؤوس نووية حرارية ويمكن إطلاقه من غواصة.

22- R-36 آى سى يى ام R-36 ICBM
هذا القاتل المرعب لن يتحمل كثيراً من المتاعب للشروع في إحداث محرقة نووية تسفر عن آلاف الضحايا.

23- الأجسام الميتة
إن القنابل النووية والليزر تعتبر أسلحة قوية بشكل كبير. ولكن إذا أراد بعض المهووسين تدميراً بطيئاً يسبب الدمار العقلي، فإن إطلاق #الجثث المريضة على أسوار أي مدينة هو أكثر الطرق سادية لتدمير شعب بأكمله.
24- فيروسات “الكيميرا” Chimera Viruses
إن تدمير مدينة بأكملها اليوم هو ليس إلا مجرد الضغط على زر. ولكن الطريقة الوحشية والمروعة أكثر من غيرها هي عملية الإبادة ببطء لكامل سكان أي مدينة باستخدام فيروسات “الكيميرا”.
ر
شبكة رمضان الإخبارية شبكة إخبارية تهتم بشئون الجالية العربية فى النمسا ودول الجوار